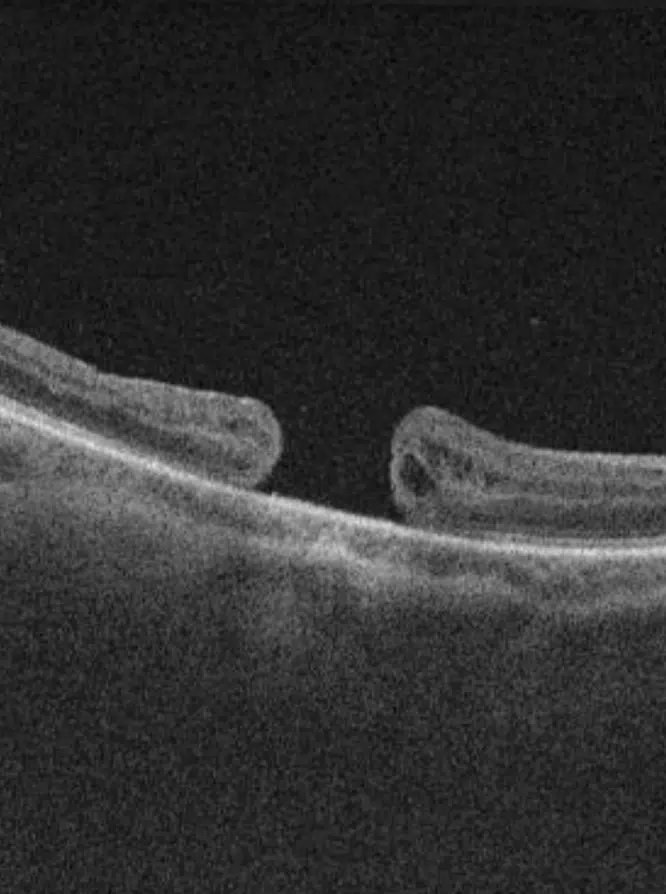

L’opération de la rétine peut être nécessaire dans des cas où la vision est directement affectée. Par exemple, un décollement de la rétine nécessite une intervention rapide pour éviter une perte de la vision. Cette chirurgie permet de rattacher la rétine et de préserver ainsi la fonction visuelle. De même, dans le cadre de la rétinopathie diabétique, où les vaisseaux rétiniens sont fragilisés, une chirurgie peut être envisagée pour stopper les hémorragies et préserver la vision. D’autres pathologies, comme la membrane épirétinienne ou le trou maculaire peuvent aussi être traitées par une intervention chirurgicale afin de réduire les déformations de la vision.
Chirurgie de la rétine
La chirurgie rétinienne permet de traiter des pathologies graves de la rétine, offrant la possibilité de préserver ou améliorer la vision. Lorsque des affections comme le décollement de la rétine ou la rétinopathie diabétique menacent la vue, l’intervention chirurgicale devient essentielle pour stopper l’évolution de la maladie et prévenir des pertes de vision permanentes. Voici les techniques utilisées par les spécialistes du Pôle Ophtalmologique de Poissy.

Les opérations de la rétine
Certaines affections de la rétine nécessitent une prise en charge chirurgicale spécialisée. Ces interventions visent à préserver la fonction visuelle et à prévenir des séquelles irréversibles.
Pourquoi opérer la rétine ?
Quelles sont les opérations de la rétine ?
La chirurgie rétinienne se divise en plusieurs types d’interventions, en fonction de l’affection à traiter.
Membrane épirétinienne ou épimaculaire
Une membrane épirétinienne ou épimaculaire se forme à la surface de la rétine et altère la vision. Pour la retirer, une vitrectomie est réalisée pour améliorer la vision centrale.
Trou maculaire
Un trou maculaire se produit lorsqu’une discontinuité de la macula perturbe la vision centrale. Une intervention chirurgicale comme la vitrectomie, souvent accompagnée d’une injection de gaz intraoculaire, permet dans la majorité des cas d’obtenir la fermeture du trou et d’améliorer la vision.
Décollement de rétine
Le décollement de rétine est une urgence chirurgicale. Plusieurs techniques chirurgicales existent ayant pour objectif de recoller la rétine afin d’éviter une perte de vision irréversible.
Hémorragie intravitréenne persistante
Les hémorragies intravitréennes surviennent lorsque du sang s’accumule dans l’œil à la suite de pathologies comme la rétinopathie diabétique. L’intervention chirurgicale permet alors de retirer le sang..
Rétinopathie diabétique
La rétinopathie diabétique peut gravement affecter la vision. Une chirurgie rétinienne permet de stabiliser la maladie et d’empêcher des complications sévères.
Se préparer à une chirurgie de la rétine
Avant toute chirurgie rétinienne, une série d’examens permet de déterminer l’approche la plus adaptée. Ils permettent au chirurgien de visualiser précisément les zones affectées et de planifier l’intervention.
L’anesthésie est généralement locale, parfois accompagnée d’une sédation légère. Le geste se pratique en ambulatoire : le patient peut regagner son domicile le jour même après quelques heures de surveillance. La durée totale de l’intervention dépasse rarement 45 à 60 minutes, mais elle peut varier selon la complexité de la pathologie. Il faut compter un total de 4 à 6 heures sur place entre toutes les étapes de la prise en charge. Les deux yeux ne seront pas opérés en même temps, chaque œil bénéficie de sa date d’intervention.
Après la chirurgie de rétine, des consignes spécifiques devront être suivies, telles que la restriction des mouvements ou la prise de médicaments pour favoriser la récupération.
Techniques complémentaires en chirurgie rétinienne
Les interventions rétiniennes peuvent être associées à des techniques complémentaires pour améliorer les résultats et optimiser la guérison.
Photocoagulation au laser
La photocoagulation au laser est utilisée pour traiter les complications vasculaires de la rétine, comme dans le cas de la rétinopathie diabétique. Elle permet de réduire le risque de cécité et de réduire la néovascularisation.
Indentation sclérale
L’indentation sclérale consiste à appliquer une pression sur la paroi oculaire afin de stabiliser la rétine après une chirurgie de décollement. Cette technique permet de maintenir la rétine en place pendant sa cicatrisation.
Injection de gaz intraoculaire
L’injection de gaz intraoculaire est souvent utilisée comme geste complémentaire pour maintenir la rétine en place après une intervention sur un trou maculaire ou un décollement. Elle joue un rôle clé dans la stabilisation postopératoire.
Injection de silicone
Dans les cas les plus complexes, une injection de silicone peut être réalisée pour maintenir la rétine en bonne position après la chirurgie. Cette technique est notamment utilisée dans les cas de décollements rétiniens sévères.

Les échanges avec les internautes
Joan
Publié le 22 janvier 2026
Pour traiter une rétinopathie diabétique débutante, privilégiez-vous les séances de laser ou les injections intraoculaires ? Est-ce que ces traitements au Pôle de Poissy permettent de stabiliser la vue sur le long terme. Merci pour votre réponse
Pôle Ophtalmologique - POPY
Publié le 10 février 2026
Bonjour,
Dans les cas de rétinopathie diabétique, seul le spécialiste peut vous orienter vers le meilleur traitement pour vos yeux, celui-ci peut effectivement comporter des injections et/ou du laser.
Nous vous invitons à prendre un rendez vous afin d’en discuter lors d’une consultation.
Bien cordialement
L’équipe du Pôle Ophtalmologique